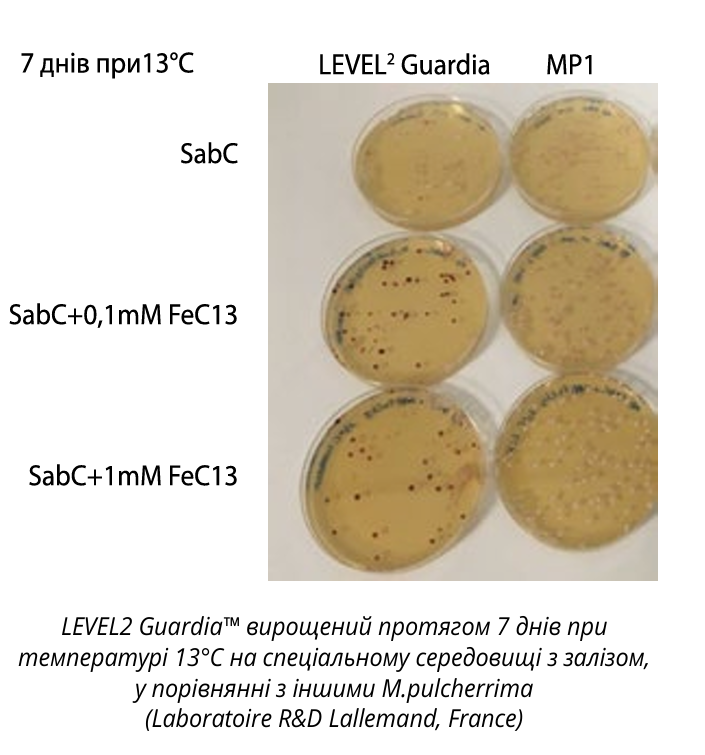

Волинський Бровар запрошує на пивний фест у Березному 1–2 серпня
Біозахист як альтернатива SO₂: дріжджі Metschnikowia pulcherrima LEVEL2 Guardia™

Зростаючий попит на вина з мінімальним вмістом сульфітів стимулює виноробів шукати безпечні біологічні рішення. Одним із найбільш перспективних інструментів є біозахист за допомогою дріжджів Metschnikowia pulcherrima LEVEL2 Guardia™, здатних контролювати мікробіальне забруднення ще до початку бродіння. Цей підхід відкриває шлях до стабільнішого та якіснішого виробництва червоних вин.
Для біозахисту були розроблені альтернативні біологічні рішення, які дозволяють контролювати мікробіальне забруднення та водночас зменшити застосування SO₂. Один із принципів біозахисту ґрунтується на управлінні популяціями шкідливих мікроорганізмів, а не їх знищенні. Це особливо важливо в умовах глобального потепління, коли підвищення pH робить SO₂ менш ефективним.
З огляду на постійний інтерес до селекції нових штамів Saccharomyces cerevisiae та Oenococcus oeni, велика увага приділяється також видам, що не належать до Saccharomyces, і можуть природно забезпечувати біозахист. Одним із таких є Metschnikowia pulcherrima.
LEVEL2 Guardia™: потужна антимікробна дія в червоних винах
LEVEL2 Guardia™ – новітній штам M. pulcherrima в портфелі, селекціонований Institut Français de la Vigne et du Vin (Бургундія). Він особливо ефективний на етапі перед бродінням червоного вина, завдяки здатності контролювати забруднення іншими мікроорганізмами.
У виноградному суслі LEVEL2 Guardia™ швидко розмножується і займає середовище, витісняючи інші види, навіть при низьких температурах.
Піно Нуар 2020 (IFV Beaune, Франція): під час холодної мацерації (5 днів, 10°C) спостерігалося зменшення популяції Hanseniaspora uvarum та інших дріжджів у порівнянні з контролем із додаванням SO₂.
Гренаш 2020 (INCAVI, Іспанія): підтвердив добру імплантацію LEVEL2 Guardia™ та виражену протимікробну дію протягом холодної мацерації, що призвело до зниження летючої кислотності після завершення бродіння. Кількість забруднюючих видів, таких як Hanseniaspora, значно зменшилась.
Чому LEVEL2 Guardia™ такий ефективний?
M. pulcherrima має унікальну властивість – виділяти пульхеримову кислоту, яка хелатує вільне залізо. У середовищі формується пульчімін, і запаси заліза виснажуються. Це пригнічує ріст забруднюючих дріжджів та бактерій, оскільки залізо є необхідним для їх розвитку.
Важливо, що завдяки наявності специфічних генів винні дріжджі S. cerevisiae здатні засвоювати залізо, зв’язане з пульхеримовою кислотою. Таким чином вони не втрачають здатності завершувати бродіння.
Синергія з Saccharomyces cerevisiae
Практика показала, що інокуляція S. cerevisiae після застосування LEVEL2 Guardia™ дає ще кращі результати, оскільки стартове середовище вже очищене від контамінантів. Це позитивно впливає на перебіг бродіння та стабільність вина.
Висновки
На етапі перед бродінням сусло особливо вразливе до небажаної мікрофлори. Щоб уникнути сенсорних дефектів, потрібен захист із самого початку виробничого процесу.
LEVEL2 Guardia™ довів ефективність як біологічна альтернатива SO₂ під час холодної мацерації червоних виноградів, забезпечуючи широкий спектр мікробіологічного захисту без компромісів у якості.
ТзОВ «Біомастер», Україна
м. Київ, вул. Клавдіївська, 23/15, к. 124
+38 (044) 355 01 91, +38 (068) 095 45 08
e-mail: info@biomaster.com.ua
Винороб Валентина Чигринець
тел.: +38 (068) 492 21 63
enolog.biomaster@ukr.net
www.biomaster.com.ua
www.facebook.com/biomaster.com.ua
Lallemand, Croatia
Nenad Maslek, dipl ing,
Area manager
mob.: +385 98 302 462
e-mail: nmaskek@lallemand.com
www.lallemandwine.com
Читайте також: Від тренінгів до інновацій: досвід Chateau Pauk та рекомендації фахівців
А ще більше цікавих статей про виноробство, пивоваріння ви можете прочитати у наших журналах. Електронна версія доступна до завантаження безкоштовно на період війни: https://techdrinks.info/archive/.
Журнал «Напої. Технології та Інновації» виходить друком у форматі «перевертайко» 2 в 1 з журналом «Пиво. Технології та Інновації». Адже з початку воєнного стану два видання «Напої. Т. І.» та «Пиво. Т. І.» об’єдналися і виходять одночасно.
Детальніше про ціни та передплату читайте тут.
Щоб придбати друкований випуск нового журналу або
передплатити видання на 2025 рік, звертайтеся за контактами:
Лариса Товкач, менеджер, +38 097 968 95 16, sad.nti@ukr.net
Анна Панкратенкова, тел.: +38 097 75 92 583, reklama.nti@gmail.com
Ірина Петронюк, тел.: +38 096 49 16 692, oksana.buh.ti@gmail.com
Ціна одного примірника журналу «Напої & Пиво. Технології та Інновації» – 300 грн. Ціна одного примірника журналу «Ягідник» – 240 грн. Ціна одного примірника журналу «Садівництво та Овочівництво. Т.І. & Горішник» – 240 грн.
Передплата триває!